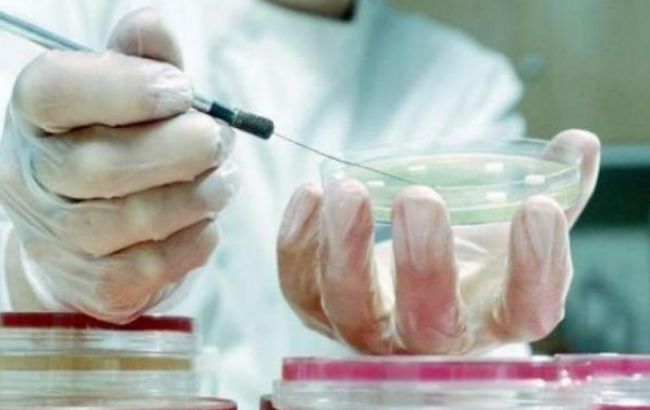

Состояние здоровья детей и взрослых медики описывают как удовлетворительное.
Количество людей, которые отравились в процессе фестиваля «Перлина Кам’янця» в Каменец-Подольском Хмельницкой области, выросло до 56. Чем именно они отравились, пока неизвестно, ведь в фестивале принимали участие больше ста человек, а нездоровье ощутили только несколько.
Предварительный диагноз госпитализированных — острая кишечная инфекция средней тяжести.
Согласно сообщению национальной службы Украины по задачам безопасности пищевых продуктов и защите покупателей, по состоянию на утро вторника в стационаре остался только тринадцатилетний ребенок.
По располагаемой последней информации ведомства, все заболевшие в период с 19-го по 21 ноября жили и питались в отельно-ресторанном комплексе «Ксения» в Каменец-Подольском. Всего там находились 227 человек из 6-ти областей Украины.
Для установления обстоятельств отравлений в городе создана специальная комиссия.
От острой кишечной инфекции в Каменце-Подольском пострадали 48 детей и 8 взрослых, которые проживали в гостинично-ресторанном комплексе «Ксения». Для лабораторных исследований отобраны пробы пищевых продуктов, смывы, пробы питьевой воды, обследуются контактные лица.
Причины отравления пока не установлены. Скорее всего, угодила сальмонелла. Об этом сказал заместитель основного доктора Броварской клиники Григорий Павлин.
«По каким-то причинам это дело замяли», — сообщил он, добавив при всем этом, что 11 детей находятся в Броварской клинике, трое — в столице.
